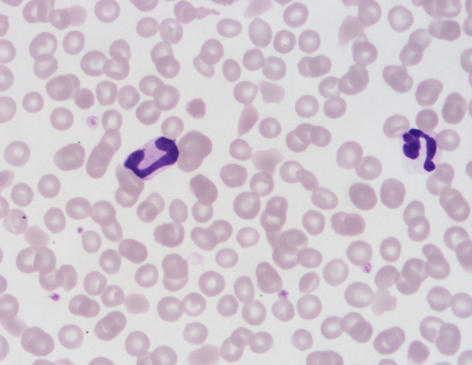
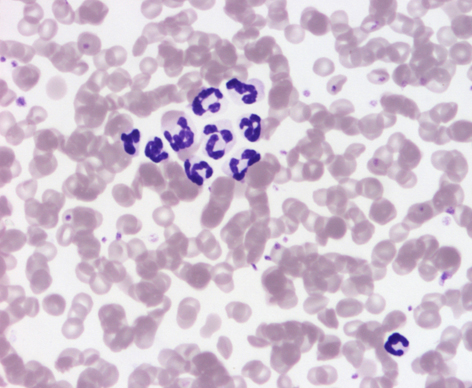

Leucocitos granulocíticos
Sus características histológicas
Los granulocitos son leucocitos caracterizados por tener numerosos gránulos en su citoplasma. Cada granulocito recibe su nombre por la apetencia tintorial de sus gránulos. Además, el núcleo de estas células está lobulado, y el número y forma de sus lobulaciones también es característico de cada granulocito.
En mamíferos se diferencian tres tipos de granulocitos: los neutrófilos, los eosinófilos y los basófilos.
Los neutrófilos también se son denominados leucocitos polimorfonucleares por las múltiples lobulaciones que puede tener su núcleo. En los neutrófilos jóvenes, el núcleo tiene forma de cayado, y conforme envejece aumentan las lobulaciones. En las hembras se puede ver la cromatina sexual o de Barr adosada al núcleo a manera de palillo de tambor. Sus gránulos tienen escasa afinidad por los colorantes.
Los eosinófilos tienen el núcleo bilobulado, aunque en la rata y el ratón forma de "roscón de Reyes". Los gránulos se tiñen intensamente eosinofílos. En el caballo, los gránulos están tan desarrollados que le dan aspecto de "mora".
Los basófilos tienen un núcleo grande, también bilobulado, aunque generalmente está oculto por los numerosos gránulos grandes y azulados (basófilos) del citoplasma.
Las aves también tienen tres tipos de granulocitos: los heterófilos, eosinófilos y basófilos. Los eosinófilos y basófilos son semejantes a las células mamíferas. Los heterófilos equivalen a los neutrófilos, pero su núcleo suele ser bilobulado, y sus granulocitos carecen de la enzima mieloperoxidasa, característica de los neutrófilos.